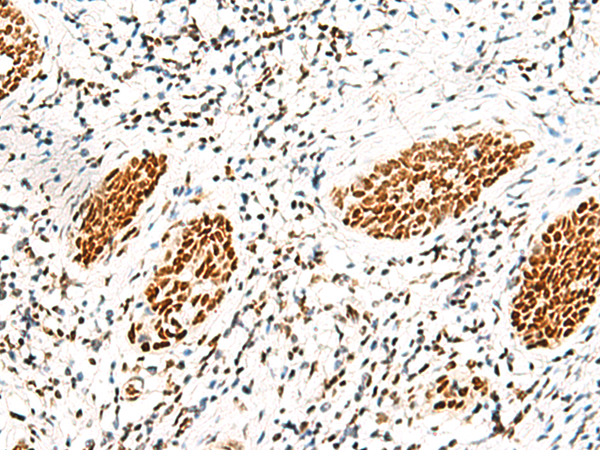
一抗

抗 原: HNRNPAB
宿 主: Rabbit
克隆類型: rabbit polyclonal
技術(shù)規(guī)格
|
Background: |
This gene belongs to the subfamily of ubiquitously expressed heterogeneous nuclear ribonucleoproteins (hnRNPs). The hnRNPs are produced by RNA polymerase II and are components of the heterogeneous nuclear RNA (hnRNA) complexes. They are associated with pre-mRNAs in the nucleus and appear to influence pre-mRNA processing and other aspects of mRNA metabolism and transport. While all of the hnRNPs are present in the nucleus, some seem to shuttle between the nucleus and the cytoplasm. The hnRNP proteins have distinct nucleic acid binding properties. The protein encoded by this gene, which binds to one of the components of the multiprotein editosome complex, has two repeats of quasi-RRM (RNA recognition motif) domains that bind to RNAs. Two alternatively spliced transcript variants encoding different isoforms have been described for this gene. |
|
Applications: |
ELISA, WB, IHC |
|
Name of antibody: |
HNRNPAB |
|
Immunogen: |
Synthetic peptide of human HNRNPAB |
|
Full name: |
heterogeneous nuclear ribonucleoprotein A/B |
|
Synonyms: |
ABBP1; HNRPAB |
|
SwissProt: |
Q99729 |
|
ELISA Recommended dilution: |
5000-10000 |
|
IHC positive control: |
Human esophagus cancer |
|
IHC Recommend dilution: |
20-100 |
|
WB Predicted band size: |
36 kDa |
|
WB Positive control: |
Jurkat cell lysate |
|
WB Recommended dilution: |
200-1000 |




 購物車
購物車 幫助
幫助
 021-54845833/15800441009
021-54845833/15800441009